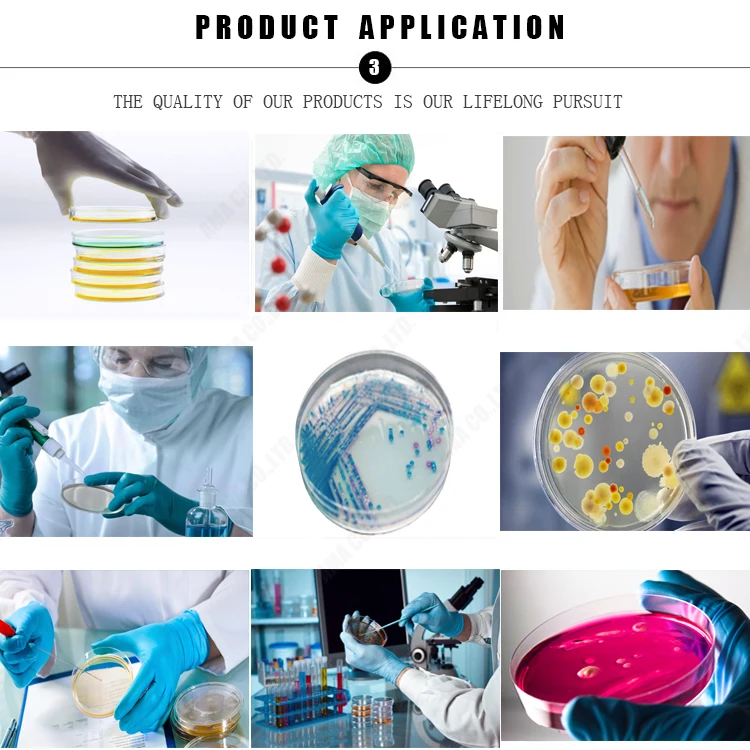

Одноразовая Стерильная пластиковая чаша Петри 55*15 мм поверхность микробного образца контактная с сетчатой тарелкой для
- Категории: Lab Supplies >>>
- Поставщик: Qingdao,Ama,Co.,Ltd.
Поделиться:
Описание и отзывы
Характеристики

Преимущества товара:
1) Утверждение CE ISO утвержденных одноразовые пластиковые чашки Петри 35 60 65 70 75 90 150 мм sterilem
2) чашку Петри, гладкая, И Коэффициент светопропускания может помочь наблюдать рост бактерий и количество бактерий.
3) поднятые линии на крышке укрепит воздухопроницаемость продукта.
4)EO Стерильная, Электронным пучком и GAMMA ray стерилизации.
5) чашку Петри имеет умеренно плотная крышка.

CE ISO утвержденных одноразовые пластиковые чашки Петри 35 60 65 70 75 90 150 мм стерильные
|
Модель изделия |
Материал |
Кол-во/Сумка |
Кол-во/ctn |
|
35x15 мм чашка Петри |
PS |
20 |
2600 |
|
60x15 мм чашка Петри |
PS |
26 |
1040 |
|
65x15 мм чашка Петри (Сетка количество) |
PS |
20 |
1000 |
|
70x15 мм чашка Петри |
PS |
20 |
700 |
|
75x15 мм чашка Петри (Два динамика) |
PS |
10 |
360 |
|
90x15 мм чашка Петри |
PS |
10 |
500 |
|
90x15 мм чашка Петри (Две решетки) |
PS |
10 |
500 |
|
90x15 мм чашка Петри (Три) |
PS |
10 |
500 |
|
90x20 мм чашка Петри |
PS |
15 |
375 |
|
150x15 мм чашка Петри |
PS |
10 |
180 |
CE ISO утвержденных одноразовые пластиковые чашки Петри 35 60 65 70 75 90 150 мм стерильные

Циндао AMA обратную связь о том, что вы хотите о том, что вы хотите. Найдено в 1992, штаб-квартира в Тайване и производственной базой в Циндао. Она специализируется на производстве одноразовые медицинские тестирования продуктов. AMA создала целый набор строгая внутренняя система контроля качества и прошли ISO9001,ISO13485 древесных гранул производственной линии Утверждение CE.
AMA добилась больших достижений: это вакуумная трубка для крови, пробирки, чашка Петри и культура тканей растений обладают высокой пользуются, в частности, в Соединенных Штатах Америки, Японии и Иордания рынка.

Мы стала известной фирмы в области медицинских и лабораторных изделий в Китае, У нас есть большое количество клиентов и дилеров по всей стране, производство и маркетинг все в одном обслуживании.В настоящее время он считается бывшим в являясь лидером в области одноразовые медицинские изделия.

CE ISO утвержденных одноразовые пластиковые чашки Петри 35 60 65 70 75 90 150 мм стерильные
Профессиональный технический дизайн будет поддержку вашей покупкой, свяжитесь с18863608211[@]163.com Для получения более подробной информации.

Контактные данные18863608211[@]163.comВы сможете увидеть больше товаров.

Мы предлагаем OEM продукты, таким образом, чтобы условия упаковки могут быть настроены по требованию клиента. И наши Транспортные агентства, предоставит вам самый лучший сервис доставки. Откуда вы? Напишите мне и позвольте мне узнать стоимость доставки в вашу страну18863608211[@]163.com

Профессиональный технический дизайн будет поддержку вашей покупкой, свяжитесь с18863608211[@]163.com Для получения более подробной информации.

Q1: Что насчет качества?
Продукция от производителя (Сертификация CE & ISO подтверждены. Мы имеем более чем 20-летний опыт работы в производство и продажа машин по переработке шин в лабораторное оборудование, мы завоевали хорошую репутацию на рынке.
Q2: какие Способы оплаты доступны?
T/T (банковский пеервод), L/C, PayPal, Western Union и MoneyGram.
Q3: Можете ли вы производить в соответствии с дизайном покупателей?
Да, мы являемся профессиональным производителем надувных лодок; OEM и ODM-оба приветствуются.
Q4: можем ли мы посетить вашу фабрику?
Конечно, добро пожаловать на нашу фабрику, рады вашему визиту в том случае, если вы приедете в Китай.
Q5: Как долго длится срок действительности расценки?
Как правило, наша цена действительна в течение одного месяца после даты котирования. Цена будет скорректирован должным образом как колебание цены сырья на рынке.























